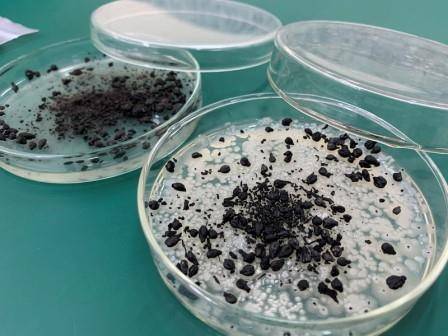

Segundo o 8º levantamento da safra 2021/2022, recém divulgado pela Companhia Nacional de Abastecimento (Conab), a produção dos grãos cultivados na segunda safra e dos cereais de inverno deve aumentar nas lavouras sul-mato-grossenses. De acordo com a atualização dos números, o estado deve chegar a uma produção de 20,7 milhões de toneladas, 9,1% a mais que a safra anterior, quando alcançou 18,9 milhões de toneladas. Embora os resultados sejam promissores, o estado tem total condições de evoluir ainda mais, principalmente com a ajuda da tecnologia.
Um projeto de pesquisa liderado pela Universidade de Passo Fundo (UPF) em conjunto com a Universidade Federal de Santa Maria (UFSM), une a vocação de uma região do estado ao desenvolvimento de uma solução para o setor agrícola e à preservação ambiental. O estudo está desenvolvendo um biochar (um carvão de origem vegetal) a partir dos resíduos do processamento de uvas na indústria vinícola, que será usado para reter microrganismos benéficos para o solo. Esse produto, ao ser adicionado aos adubos químicos, pode reduzir as quantidades necessárias nas aplicações de fertilizantes nas lavouras.
A iniciativa é uma parceria com as empresas Adubos Coxilha e a Beifiur Ltda, e conta com o apoio da Secretaria de Inovação, Ciência e Tecnologia do Governo do Estado do Rio Grande do Sul, por meio do programa Techfuturo.
No biochar, são imobilizados microorganismos promotores do crescimento das plantas. Ao incorporar esse material em adubos químicos, a liberação dos nutrientes para as plantações ocorre de forma sinérgica, potencializando seus efeitos e possibilitando, conforme testes futuros, reduzir a dosagem de fertilizantes químicos convencionais, insumos importados dos quais o Brasil é bastante dependente.
O pesquisador responsável pelo projeto na UPF, Jeferson Steffanello Piccin, conta que a ideia surgiu dentro dos laboratórios da pós-graduação da universidade e a partir de uma necessidade tanto dos produtores rurais como da indústria, uma vez que a destinação das cascas, sementes e bagaço da uva são um desafio para o setor vitivinícola. “Alinhamos a proposta de pegar a parte de microorganismos e bioinsumos, pesquisadas na empresa Beifuir, e unir com a parte de adubos convencionais da empresa Adubos Coxilha. E a partir dessa colaboração, pretendemos entregar uma solução que faça a diferença nas lavouras e ainda contribua com o meio-ambiente”, explica o docente, que é engenheiro de alimentos e doutor em Engenharia Química.
Ele lembra que, quando as empresas foram procuradas para firmar a parceria, ambas aceitaram de imediato. “Vemos que nós, como professores e pesquisadores de instituições de ensino, temos que nos aproximar mais das indústrias e do setor produtivo, uma vez que é possível fazer pesquisas inovadoras e entregar ao setor, além de conhecimento, novas soluções, processos e tecnologias”, observa.
Conexão entre a universidade e o campo
O projeto conta com três fases. A primeira é a de desenvolvimento do biochar. Na sequência, será feita a imobilização dos microrganismos no “carvão” desenvolvido. Por fim, o produto será adicionado ao fertilizante para os testes no campo, que serão realizados na Universidade de Passo Fundo, em cultivares como trigo, soja e também hortaliças. Serão analisados critérios como pureza, concentração e tempo de prateleira do produto, além da avaliação da eficiência agronômica em casa de vegetação e em campo.
concentração e tempo de prateleira do adubo, além da eficiência agronômica
Foto: Tainá Binelo
Doutoranda envolvida no projeto, Flávia Melara ressalta que o estudo propõe uma forma inovadora de inserir esta tecnologia no campo. “Em culturas como milho e trigo, por exemplo, o novo produto pode permitir que o controle seja aplicado no período ideal garantindo que os nutrientes tenham maior aproveitamento pelas plantas, gerando mais produtividade e, até mesmo, diminuindo as doses aplicadas ao longo do tempo”, pontua. Ela acrescenta que o desafio é fazer com que os microrganismos permaneçam viáveis quando forem imobilizados no biochar e mantenham alta concentração e pureza até aplicação em campo.
Parceria para acelerar processos
A Beifiur Ltda possui laboratórios de pesquisa, biofábrica e linha de produção de fertilizantes orgânicos onde parte da pesquisa com os microrganismos e com o biochar de resíduos de uva é desenvolvida. Para Valdecir Ferrari, sócio administrador, o estudo está em linha com o objetivo da empresa de colocar no mercado produtos menos tóxicos e mais benéficos para o meio ambiente. “A pesquisa é desafiadora. Atiramos em várias áreas e nem sempre acertamos. Mas com a soma de esforços e com persistência, visão técnica e científica, é possível acelerar o tempo de desenvolvimento e fazer com que o produto chegue mais rápido ao consumidor, garantindo sustentabilidade econômica, ambiental e social”, destaca.
A Adubos Coxilha possui equipe técnica que irá auxiliar desde a produção do fertilizante com biotecnologia até os testes a campo desta nova tecnologia. Além disso, a produção dos fertilizante em maiores volumes será realizada em sua planta localizada em Tapejara. “O projeto é inovador e representa o que a empresa busca, que é oferecer ao produtor rural fertilizantes com tecnologia que melhorem a produtividade de suas lavouras. Esperamos um impacto positivo, pois certamente estaremos contribuindo para o desenvolvimento de uma agricultura cada vez mais sustentável e comprometida com a preservação do meio ambiente”, afirma Gilberto Borgo, vice-presidente da Adubos Coxilha.
Dependência externa Além de dificultar a importação de fertilizantes, a guerra na Ucrânia também provocou uma disparada nos preços desses produtos. Para os produtores de soja, por exemplo, o custo com esses insumos triplicou. Em março, o Ministério da Agricultura, Pecuária e Abastecimento (Mapa) lançou o Plano Nacional de Fertilizantes, com o objetivo de reduzir a dependência de insumos importados e promover autossuficiência para o setor no longo prazo. A ideia é atingir este patamar em 30 anos. Hoje, entre 70% e 80% dos fertilizantes usados em solo brasileiro são importados. Esses produtos representam de 30% a 40% dos custos de produção do agronegócio.